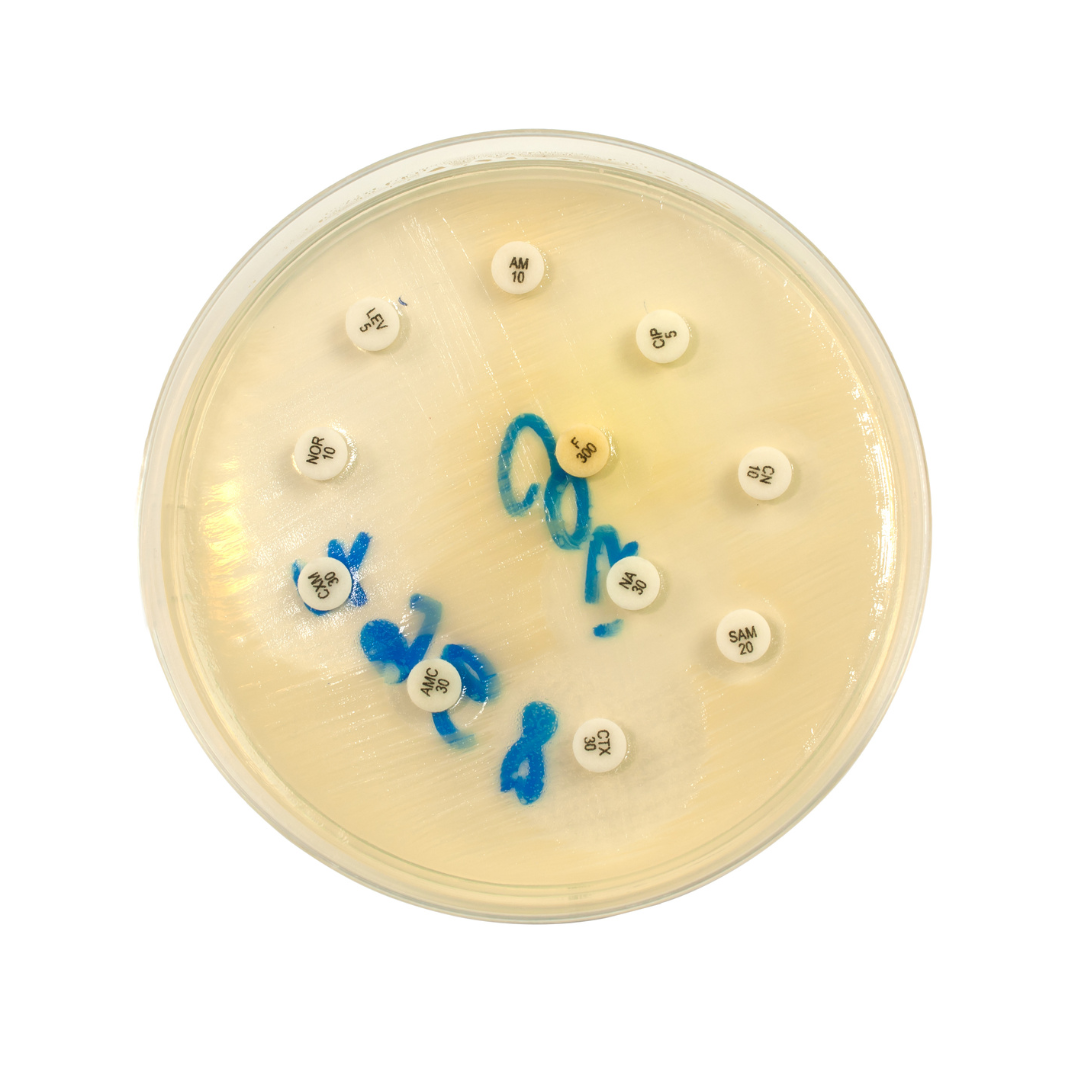
testes de suscetibilidade antimicrobiana

Os testes de suscetibilidade antimicrobiana podem fazer parte da rotina de quem tem fibrose cística, mas você sabe o que eles são e a sua importância para quem tem a doença? Para responder essas e outras perguntas o Unidos pela Vida – Instituto Brasileiro de Atenção à Fibrose Cística entrevistou a biomédica Jannaina F. de Melo Vasco*. Confira!
O teste de suscetibilidade antimicrobiana é um tipo de teste que vai detectar o perfil de susceptibilidade dos microrganismos frente aos antimicrobianos. E por que a gente usa esse termo “susceptibilidade” e não sensibilidade? Porque nos testes serão determinados a sensibilidade, a resistência ou ainda o perfil intermediário das bactérias frente aos antimicrobianos, sendo que, na maioria dos casos, esses antimicrobianos são antibióticos testados contra essas bactérias.
O teste de suscetibilidade aos antimicrobianos (TSA), popularmente conhecido como antibiograma, baseia-se na determinação da capacidade de um microrganismo, como bactéria ou fungo, de se multiplicar in vitro, ou seja, nos meios de cultura, na presença de diferentes fármacos, que são os antimicrobianos.
Para avaliar in vitro a susceptibilidade bacteriana frente aos antimicrobianos, podemos usar várias metodologias. Uma delas é o método de diluição, na qual se utiliza meios de cultura líquidos, chamados de caldos, ou sólidos, chamados de ágares, adicionados de concentrações crescentes de um determinado antibiótico. Esses testes do método de diluição são quantitativos e vão determinar a concentração inibitória mínima (CIM) do antimicrobiano (mg/dl), necessário para inibir o crescimento bacteriano.
Outro método também quantitativo é o método automatizado, no qual utiliza-se aparelhos de automação. Esses aparelhos detectam a CIM do antimicrobiano de maneira rápida e eficaz frente aos microrganismos testados e isolados. Nesse método tem-se o resultado de forma mais rápida do que no método de diluição, para o correto direcionamento do tratamento.
Por fim, o mais utilizado nos laboratórios clínicos nos setores de microbiologia, é o método de Kirby-bauer ou disco-difusão. Nesse teste são utilizados meios de cultura sólidos (ágares) e discos de papel impregnados com diferentes antimicrobianos, no qual serão lidos o tamanho ou a presença de halos de inibição. Sendo esse método qualitativo e seus resultados, a partir da presença ou ausência dos halos, serão expressos em sensível, intermediário ou resistente.
O TSA, independentemente da metodologia utilizada, deve ser realizado sempre que se isola em cultura um microrganismo causador de alguma doença infecciosa, e o médico precisará tratar essa doença.
Sendo assim, o TSA vai servir para guiar a terapêutica, ou seja, para direcionar o tratamento contra aquele microrganismo identificado e isolado em uma doença infecciosa. O teste vai identificar quais são os antimicrobianos aos quais o microrganismo é resistente, ou seja, que não se pode tratar com aquele antibiótico, quais são sensíveis, que pode ser então uma opção de tratamento; ou intermediários.
Portanto, como citado anteriormente, o TSA é de extrema importância para guiar a terapêutica. Podendo o clínico se utilizar desse resultado para realizar um tratamento de “terapia alvo” e não mais de maneira empírica. O teste possibilitará conhecer o perfil de susceptibilidade do microrganismo, e assim, aumenta-se as chances do sucesso terapêutico.
O teste de susceptibilidade também é importante para a detecção de cepas bacterianas emergentes e resistentes aos fármacos utilizados no tratamento das infecções, as bactérias conhecidas como multirresistentes ou pan-resistentes, ou de difícil tratamento.
Na fibrose cística esses testes são comumente utilizados quando se suspeita de algum processo infeccioso, como as infecções pulmonares. Mas, esses testes também podem ser utilizados em vários outros tipos de infecções, como por exemplo, infecções da pele, ouvido, garganta e até mesmo infecções sistêmicas, como as urinárias, da corrente sanguínea, entre outras.
Eles são importantes pois ajudam na identificação do correto e rápido tratamento das doenças infecciosas, principalmente na doença pulmonar. Assim, aumenta-se as chances de cura e bloqueio da disseminação daquele microrganismo que esteja causando a doença infecciosa, visto que por meio do TSA irá ocorrer um tratamento correto e rápido da infecção.
Quando se conhece o perfil de suscetibilidade de uma bactéria, podem ser utilizados antibióticos voltados diretamente para o alvo, ao invés de utilizar medicamentos de forma empírica que, na maioria das vezes, serão antibióticos de amplo espectro, ou seja, vão atingir uma ampla gama de microrganismos, podendo inclusive danificar a microbiota própria.
Na fibrose cística existe um cuidado muito grande com as doenças pulmonares causadas por patógenos padrões e já conhecidos no cenário da patologia, pois danificam de maneira muito severa o pulmão. Portanto, quando se detecta e trata corretamente esses patógenos, podemos salvar vidas e melhorar muito o prognóstico da pessoa com fibrose cística.
Os testes podem ser utilizados na fibrose cística, quando tem-se infecções por bactérias como Pseudomonas aeruginosa, Staphylococcus aureus (MRSA), complexo Burkholderia cepacia, dentre outras. Então, quando tem-se esses patógenos isolados de uma amostra respiratória, é muito importante que o tratamento seja realizado de maneira eficaz e rápida, e para isso, é preciso conhecer o perfil de susceptibilidade dessas bactérias, aumentando as chances de erradicação desses patógenos e eliminação da infecção pulmonar.
*Jannaina F. de Melo Vasco é biomédica (CRBM-6 no 004) formada pela Pontifícia Universidade de Goiás (UCG-GO). Especialista em Microbiologia Clínica e Micologia Clínica pela Pontifícia Católica do Paraná (PUC-PR). Mestre em Microbiologia, Parasitologia e Patologia pela Universidade Federal do Paraná (UFPR). Doutoranda pelo Programa de Pós-graduação Saúde da Criança e do Adolescente da Universidade Federal do Paraná (UFPR) com o tema “Microbioma pulmonar e gastrointestinal na criança com fibrose cística” sob a orientação do médico pneumologista pediatra Dr. Nelson Rosário Filho. Conselheira diretora primeira-secretária do Conselho Regional de Biomedicina do Paraná (CRBM-6). Presidente da Comissão de Ética do CRBM-6. Docente e supervisora de estágios da Universidade Tuiuti do Paraná (UTP). Tem experiência na área de Microbiologia, com ênfase em Microbiologia e Micologia Médica, atuando principalmente nos seguintes temas: microbioma respiratório e gastrointestinal da fibrose cística, microbiologia da fibrose cística, resistência bacteriana em microrganismos isolados de hemocultura de pacientes oncológicos, cultura de queimados e cultura quantitativa de biópsia.
Por Kamila Vintureli
Quer fortalecer o trabalho realizado pelo Unidos pela Vida? Clique aqui e escolha a melhor forma de fazer uma doação.
Nota importante: As informações aqui contidas têm cunho estritamente educacional. Em hipótese alguma pretendem substituir a consulta médica, a realização de exames e/ou o tratamento médico. Em caso de dúvidas, fale com seu médico.




Segunda à sexta | 9h às 18h
O time do Unidos pela Vida atua em home office. Caso precise falar conosco, utilize um dos meios de contato.
Inscreva-se em nossa newsletter para receber notícias, avisos, alertas importantes e fique por dentro de tudo que acontece em nosso grupo: